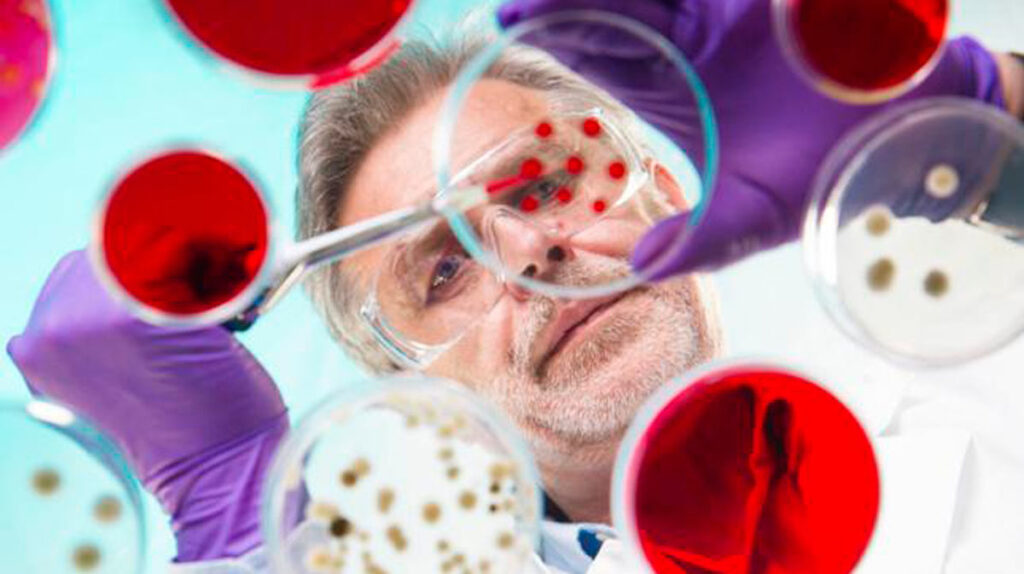

La medicina, esa ciencia primordial que ha ido evolucionando a lo largo de los años con un único propósito: alargar las vidas de los seres humanos. Una rama científica fundamental para la subsistencia que ha generado numerosos descubrimientos impresionantes durante toda sus historia.
Estas investigaciones destinadas únicamente al bienestar del ser humano, pueden definirse como un antes y un después en la subsistencia de nuestra especie. Por eso desde OK diario te mostramos los 5 descubrimientos médicos más importantes que han existido.
Anestesia
A lo largo de la historia han existido numerosas formas de anestesia. Desde la Antigua Grecia hasta la actualidad, pasando por Egipto y las Américas, esta sustancia ha ido incorporando diferentes cambios. Sin embargo, no fue hasta el siglo XIX por medio del oftalmólogo austriaco Karl Koller que la anestesia comenzó a emplearse de forma adecuada. Cabe destacar que estas primeras formulas no fueron muy pudorosas, ya que la composición de esta sustancia incorporaba pequeñas dosis de cocaína.
Penicilina
Alexander Fleming estaba estudiando distintos remedios contra la gripe en uno de sus laboratorios y accidentalmente, el científico, se fue un mes del mimo dejando una ventana abierta. Cuando regresó de su retiro, descubrió que la placa de petri que había olvidado tenía una especie de hongo que había acabado con todo su trabajo. Sin embargo, más que un fracaso, el doctor Fleming descubrió las impresionantes propiedades de los hongos Penicillium, consiguiendo así perpetuar la penicilina.
Genética
La genética puede definirse como la rama de la ciencia que estudia la herencia biológica. Es decir aquello que los seres vivos trasladamos a nuestros descendientes. Un impresionante descubrimiento que nos permite saber cuáles son los motivos por los que se producen los ciclos celulares de los organismos. Cabe destacar la importancia de Gregor Mendel en este aspecto, uno de los científicos pioneros en el descubrimiento de la genética.
Gérmenes
Corría el año 1676 cuando un científico holandés denominado Anton Van Leeuwenhoek, famoso por la creación de microoscopios, consiguió descubrir los gérmenes. Algo que realizó por medio del estudio de miles de células, dividiéndolas en bacterias y gérmenes. Un descubrimiento de enorme utilidad para el desarrollo de vacunas y avances médicos primordiales.
Vacunas
Las vacunas quizás puedan definirse como el descubrimiento más importante de la medicina. Un logro que debemos a Edward Jenner, un médico inglés que comenzó descubriendo la cura para la viruela. Una enfermedad que acechó a la población mundial con unas enormes dosis de mortalidad durante el siglo XVIII.